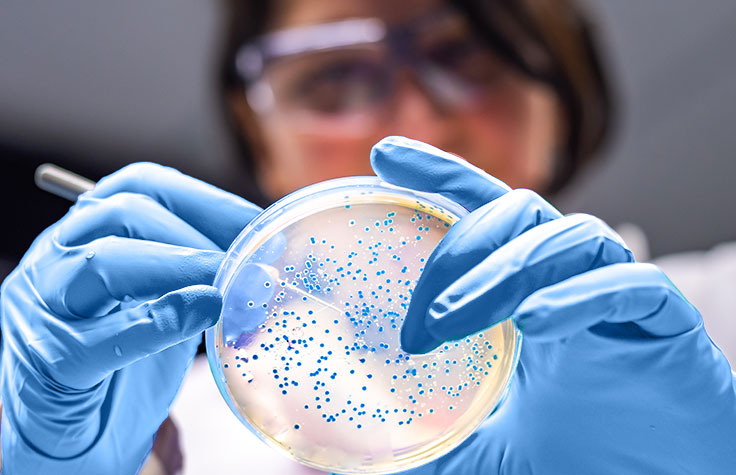
NGS is Revealing the Mysterious World of Microbes

16S和ITS rRNA测序
16S和ITS rRNA测序是什么?
16S和ITS rRNA测序(内部转录间隔区核糖体RNA测序)是常用的扩增子测序方法,可用于鉴定和比较给定样本中的细菌或真菌。基于NGS的ITS和16S rRNA基因测序可比较来自复合微生物组或环境中难以研究甚至不可能研究的样本的系统发育和分类,它们都是该应用领域的成熟方法。
原核生物的16S rRNA基因长约1500 bp,包含9个散布在保守区域之间的可变区。16S rRNA的可变区经常用于不同微生物群落的属或种系统进化分类1。rRNA顺反子的ITS1区域是鉴定宏基因组样本中真菌物种的常用DNA标记2。
使用iSeq 100系统进行16S rRNA测序
通过iSeq 100系统开展16S宏基因组学工作流程,可使菌群研究的灵敏度达到种属水平。
基于NGS的ITS和16S rRNA分析的优势
16S和ITS核糖体RNA NGS方法的一个主要优点是它们提供了一种经济高效的技术,可以鉴定传统方法可能无法发现的菌株。与毛细管测序或基于PCR的方法不同,新一代测序无需培养即可分析样本中的整个微生物群落。
微生物学家通过16S rRNA NGS可以将菌群宏基因组学研究的灵敏度提升至属水平。使用NGS进行ITS分析可以快速鉴定真菌,有助于我们深入了解真菌微生物组。此外,NGS还能在单次测序运行中分析多个样本。


16S和ITS rRNA测序的工作流程演示
Illumina提供支持16S和ITS rRNA测序的产品,从文库制备到数据分析和解读。我们演示的工作流程可以帮助您消除实验中的相关猜测。
点击下方的查看工作流程各步骤所使用的产品。
多重样本可以提高样本通量。
具有经济实惠,快速且触手可及的测序能力,可在任何实验室进行靶向或小型基因组测序。
快速、准确、简便,适用于微生物学的深层次应用。
使用BaseSpace Apps进行分类学分类
16S Metagenomics利用Illumina审核的GreenGenes分类数据库对16S rRNA靶向扩增子read进行分类学分类。
DRAGEN Metagenomics Pipeline进行read物种分类,并提供单个样本和汇总报告。
经常一并购买
16s rRNA Sequencing FAQs
相关产品
参考文献
- Weisburg WG, Barns SM, Pelletier DA, Lane DJ. 16S ribosomal DNA amplification for phylogenetic study. J Bacteriol. 1991;173(2):697–703
- Schoch CL, Seifert KA, Huhndorf S, et al. Nuclear ribosomal internal transcribed spacer (ITS) region as a universal DNA barcode marker for Fungi. Proc Natl Acad Sci. 2012;109(16):6241-6
- The Human Microbiome Project Consortium (2012) Structure, function and diversity of the healthy human microbiome. Nature 486:207–14.
- McCafferty J, Mühlbauer M, Gharaibeh RZ, Arthur JC, Perez-Chanona E., et al. (2013) Stochastic changes over time and not founder effects drive cage effects in microbial community assembly in a mouse model. ISME Journal doi: 10.1038/ismej.2013.106.